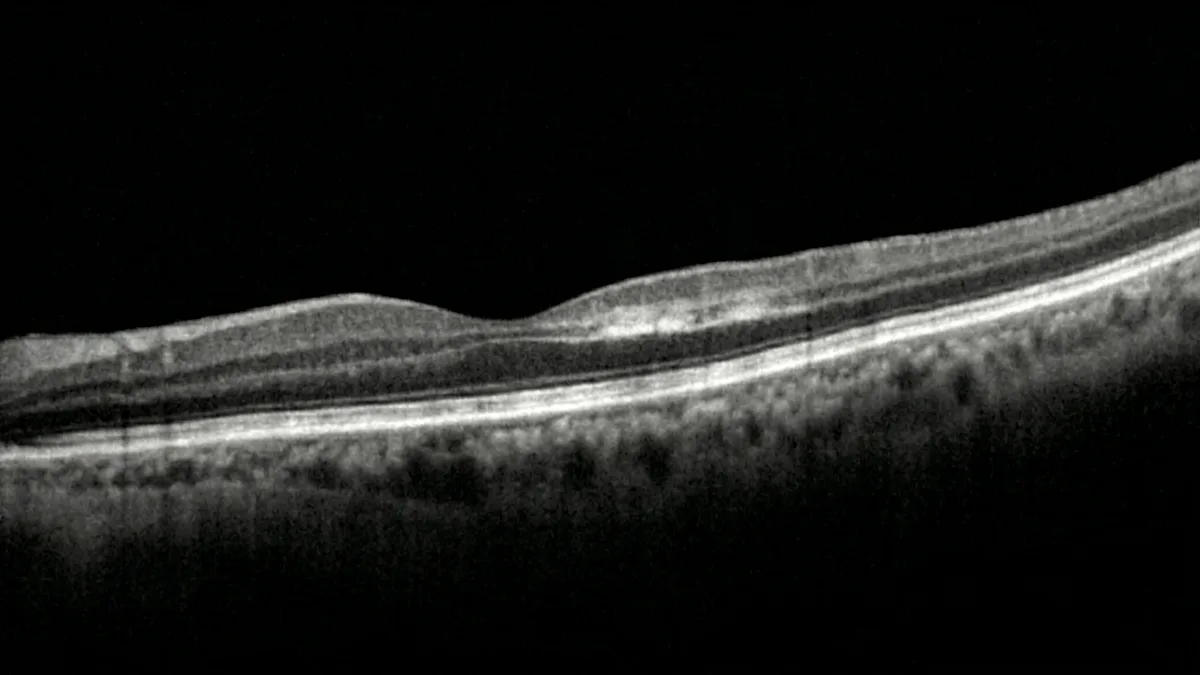
旁中心急性中层黄斑病变：诊断与治疗管理

旁中心急性中层黄斑病变是一种近年来被独立识别的视网膜缺血性疾病,累及黄斑区视网膜的中间层。朱利安·古兹兰医生,巴黎16区专注于视网膜疾病与视网膜手术的眼科外科医生,为您撰写了一篇关于这一仍鲜为人知的疾病的详尽文章。我们将阐述旁中心急性中层黄斑病变的精确定义、病理生理机制、已确认的危险因素、特征性症状、现代诊断方式——尤其是OCT和OCT血管造影——以及当前的治疗管理和长期视力预后。
什么是旁中心急性中层黄斑病变?
旁中心急性中层黄斑病变于2013年由萨拉夫及其合作者在《视网膜》杂志上首次描述。该病种对应于一种急性缺血事件,特异性地累及视网膜中间层,尤其是内核层和内丛状层。与累及浅层的经典视网膜血管阻塞(视网膜分支静脉或动脉阻塞)不同,旁中心急性中层黄斑病变源于黄斑深层毛细血管丛的损害。
在血管层面,视网膜由两个独立的毛细血管网络供血:浅层丛和深层丛。旁中心急性中层黄斑病变表现为深层丛的选择性缺血,这使其区别于其他形式的视网膜缺血。这种区分得益于视网膜影像技术的进步,特别是频域OCT和OCT血管造影,它们能够以微米级分辨率逐层分析视网膜。
旁中心急性中层黄斑病变的病因和危险因素
旁中心急性中层黄斑病变的病理生理基础是黄斑深层毛细血管丛的急性低灌注。文献中已报道了多种与该疾病相关的临床背景(拉希米等,《视网膜》,2015年;陈等,《美国眼科杂志》,2015年):
- 心血管疾病:高血压、动脉粥样硬化、栓塞性心脏病、脑血管意外病史。
- 视网膜血管疾病:本病可单独发生,也可合并视网膜分支动脉阻塞、视网膜中央动脉阻塞,或晚期糖尿病视网膜病变。
- 高凝状态:凝血功能障碍、镰状细胞病、抗磷脂综合征。
- 医源性和中毒性原因:部分病例报道于使用血管收缩剂、大剂量咖啡因之后,或围手术期(心脏手术、长时间全身麻醉)发生。
- 视网膜性偏头痛:在偏头痛患者中已有本病的报道,提示可能存在血管痉挛机制。
- 特发性:在相当数量的病例中未找到病因,尤其是在无已知心血管危险因素的年轻患者中。
需要强调的是,本病可能是尚未诊断的全身性血管疾病的预警信号。因此,在发现本病时建议进行全面的心血管检查(于等,《眼科综述》,2018年)。
本病的症状与诊断
患者感受到的症状
本病典型表现为突然出现旁中心暗点,即视野中位于注视点附近的暗色或灰色斑点,但在大多数情况下并不直接累及注视点。患者通常描述为在数小时内出现的固定盲区或模糊区域。中心视力可能保持正常或仅轻度下降,这有时使初始临床诊断变得困难。
眼底检查
在眼底生物显微镜检查中,本病可能非常隐匿甚至不可见。有时可观察到轻微的旁中心视网膜白化区域,但如果不借助辅助影像检查,这种异常通常难以发现。
OCT:诊断的关键检查
OCT(光学相干断层扫描)是确诊本病不可或缺的检查。其特征性表现为视网膜内核层和内丛状层的带状高反射,对应于这些层细胞的缺血和细胞毒性水肿。在晚期阶段,这种高反射信号演变为内核层的变薄和萎缩,反映不可逆的细胞丧失(萨拉夫等,《视网膜》,2013年)。
OCT血管造影:深层丛的可视化
OCT血管造影是理解本病的重大进展。这项无创检查无需注射造影剂,可直接显示暗点对应区域深层毛细血管丛血流减少的情况。OCT血管造影因此证实了深层缺血机制,并有助于将本病与其他黄斑疾病进行鉴别(内米罗夫等,《视网膜》,2016年)。
本病的治疗与管理
迄今为止,本病尚无经过验证的特异性治疗方法。没有随机对照研究证实任何治愈性治疗的有效性。治疗管理主要基于以下几个方面:
- 全身性病因学检查:筛查心血管危险因素(血脂检查、血糖、血压、凝血功能检查、心脏超声、主动脉弓上血管彩色多普勒超声)。该检查至关重要,因为本病可能揭示需要紧急治疗的隐匿性血管疾病。
- 治疗基础病因:纠正心血管危险因素,根据指征进行抗凝或抗血小板治疗,管理可能存在的糖尿病或高血压。
- 定期眼科随访:通过OCT和OCT血管造影复查,跟踪视网膜病变的演变情况,并检测可能的复发或对侧眼受累。
- 无玻璃体内注射指征:与通过玻璃体内注射抗血管内皮生长因子治疗的湿性AMD(老年性黄斑变性)不同,本病不适用此类治疗,因为其机制为缺血性而非新生血管性。
本病的视力预后与病程演变
本病的视力预后因缺血的范围和部位而异。在局限性病变中,旁中心暗点可随时间部分减轻,但通常会残留功能性后遗症。OCT上可见数周内内核层的进行性萎缩,反映了不可逆的神经元丧失。
根据已发表的系列研究(拉希米等,2015年;中岛等,《BMC眼科学》,2019年),当中心凹未受累时,测量的视力恢复通常较为良好。然而,残余的旁中心暗点可能在阅读和精细操作方面造成困扰。在合并视网膜动脉阻塞的形式中,预后取决于缺血的整体范围。
本病也可能复发,尤其是在血管危险因素未得到控制的患者中。因此建议进行长期随访。
本病与鉴别诊断
本病的诊断需与以下几种可能出现类似症状的黄斑疾病进行鉴别:
- 急性黄斑神经视网膜病变:与之相近但累及视网膜外层(外核层),OCT表现不同。
- 视网膜分支动脉阻塞:浅层缺血,眼底可见更明显的视网膜白化。
- 视网膜前膜:不同的结构性病因,在OCT上清晰可见。
- 视神经病变:神经源性暗点,OCT上无视网膜内层异常。
常见问题:本病——患者常见疑问
本病是眼科急症吗?
突然出现暗点(视野中的暗斑)需要尽快进行眼科检查,最好在24至48小时内就诊。尽管本病目前没有专门的急诊治疗手段,但OCT检查对于明确诊断不可或缺。此外,本病可能是需要紧急处理的全身性血管疾病的预警信号。
本病会导致永久性视力丧失吗?
本病导致视网膜中间层缺血,进而发展为不可逆的细胞萎缩。残余的旁中心暗点通常为永久性的,但如果中心凹未直接受累,中心视力一般能够保留。因此,功能影响因病变的部位和范围而因人而异。
如何诊断本病?
诊断主要依靠OCT(光学相干断层扫描),可显示视网膜中间层特征性的高反射信号。OCT血管造影作为补充检查,可显示深层毛细血管丛血流减少。单纯眼底检查可能不够充分,因为直接观察时异常表现通常非常轻微。
本病有治疗方法吗?
目前尚无经过验证的本病治愈性治疗方法。治疗管理主要包括筛查和治疗潜在的血管危险因素(高血压、糖尿病、凝血功能障碍)。通过OCT进行定期眼科随访以监测视网膜病变的演变。相关研究正在进行中,以期更好地了解该疾病并确定潜在的治疗靶点。
本病会累及双眼吗?
虽然本病多为单眼发病,但文献中已有双眼受累的病例报道,尤其是在存在全身性血管危险因素的患者中。因此,在随访过程中建议对对侧眼进行监测。全面的心血管检查也旨在降低另一只眼受累的风险。
本病与驾车:是否兼容?
旁中心暗点的存在可能影响驾驶,尤其是侧方障碍物的察觉和路牌的阅读。是否适合驾驶取决于暗点的范围和残余视力。通过视野检查和眼科医生的评估,可以确定是否仍能安全驾驶。
何时咨询朱利安·古兹兰医生?
任何突然出现的暗斑、旁中心暗点或突发视觉不适都应促使您尽快进行眼科检查。朱利安·古兹兰医生,视网膜疾病专家,配备了诊断本病及其他缺血性视网膜疾病所需的全套影像设备(频域OCT、OCT血管造影)。如果您存在心血管危险因素(糖尿病、高血压、血管疾病病史),特别建议定期进行视网膜随访,以便及早发现深层毛细血管丛的任何损害。
📍 巴黎-奥特伊眼科诊所门诊
朱利安·古兹兰医生在巴黎-奥特伊眼科诊所接待您,为您诊断和随访本病及所有视网膜疾病。凭借包含OCT和OCT血管造影在内的先进技术平台,他以严谨和关怀的态度陪伴您管理视觉健康。
在Doctolib上预约了解更多
- OCT(光学相干断层扫描):全面了解这项视网膜分层分析的关键检查。
- OCT血管造影:无需注射的视网膜血管成像原理与适应症。
- AMD(老年性黄斑变性):这种常见黄斑疾病的病因、诊断和治疗。
- 糖尿病视网膜病变:了解糖尿病相关视网膜损害及其治疗管理。